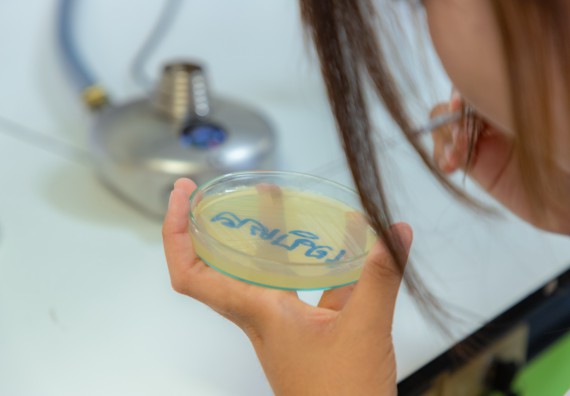
ภาพกิจกรรม  คณะวิทยาศาสตร์และเทคโนโลยี มหาวิทยาลัยราชภัฏกำแพงเพชร ร่วมกับโรงเรียนพิจิตรพิทยาคม จัดกิจกรรมเสริมปฏิบัติการเพิ่มเติมในมหาวิทยาลัย (ปฏิบัติการจุลชีววิทยา) ปีการศึกษา 2568
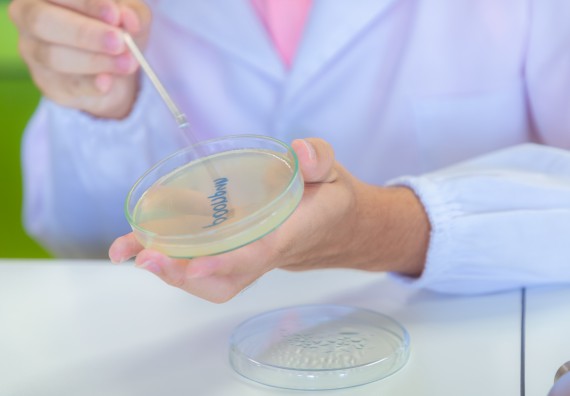
ภาพกิจกรรม  คณะวิทยาศาสตร์และเทคโนโลยี มหาวิทยาลัยราชภัฏกำแพงเพชร ร่วมกับโรงเรียนพิจิตรพิทยาคม จัดกิจกรรมเสริมปฏิบัติการเพิ่มเติมในมหาวิทยาลัย (ปฏิบัติการจุลชีววิทยา) ปีการศึกษา 2568

คณะวิทยาศาสตร์และเทคโนโลยี มหาวิทยาลัยราชภัฏกำแพงเพชร ร่วมกับโรงเรียนพิจิตรพิทยาคม จัดกิจกรรมเสริมปฏิบัติการเพิ่มเติมในมหาวิทยาลัย (ปฏิบัติการจุลชีววิทยา) ปีการศึกษา 2568 ตามโครงการพัฒนาศักยภาพห้องเรียนพิเศษวิทยาศาสตร์ฯ SMTE ม.ปลาย ปีการศึกษา 2568 ให้กับนักเรียนระดับชั้นมัธยมศึกษาปีที่ 4/11 จำนวน 30 คน โดยมีวัตถุประสงค์เพื่อให้นักเรียนมีความรู้และทักษะปฏิบัติการจุลชีววิทยาและสามารถนำความรู้ไปประยุกต์ใช้ได้ วันอาทิตย์ที่ 20 กรกฎาคม พ.ศ. 2568 เวลา 08.30-15.30 น. อาคารเรียนและปฏิบัติการทางวิทยาศาสตร์ คณะวิทยาศาสตร์และเทคโนโลยี มหาวิทยาลัยราชภัฏกำแพงเพชร กิจกรรมหลักสูตรประกอบด้วย สาขาวิชาวิทยาศาสตร์ศึกษา วิชาเอกชีววิทยา เทคนิคการย้อมสีแกรมแบคทีเรีย

งานพัฒนาสารสนเทศและงานประชาสัมพันธ์